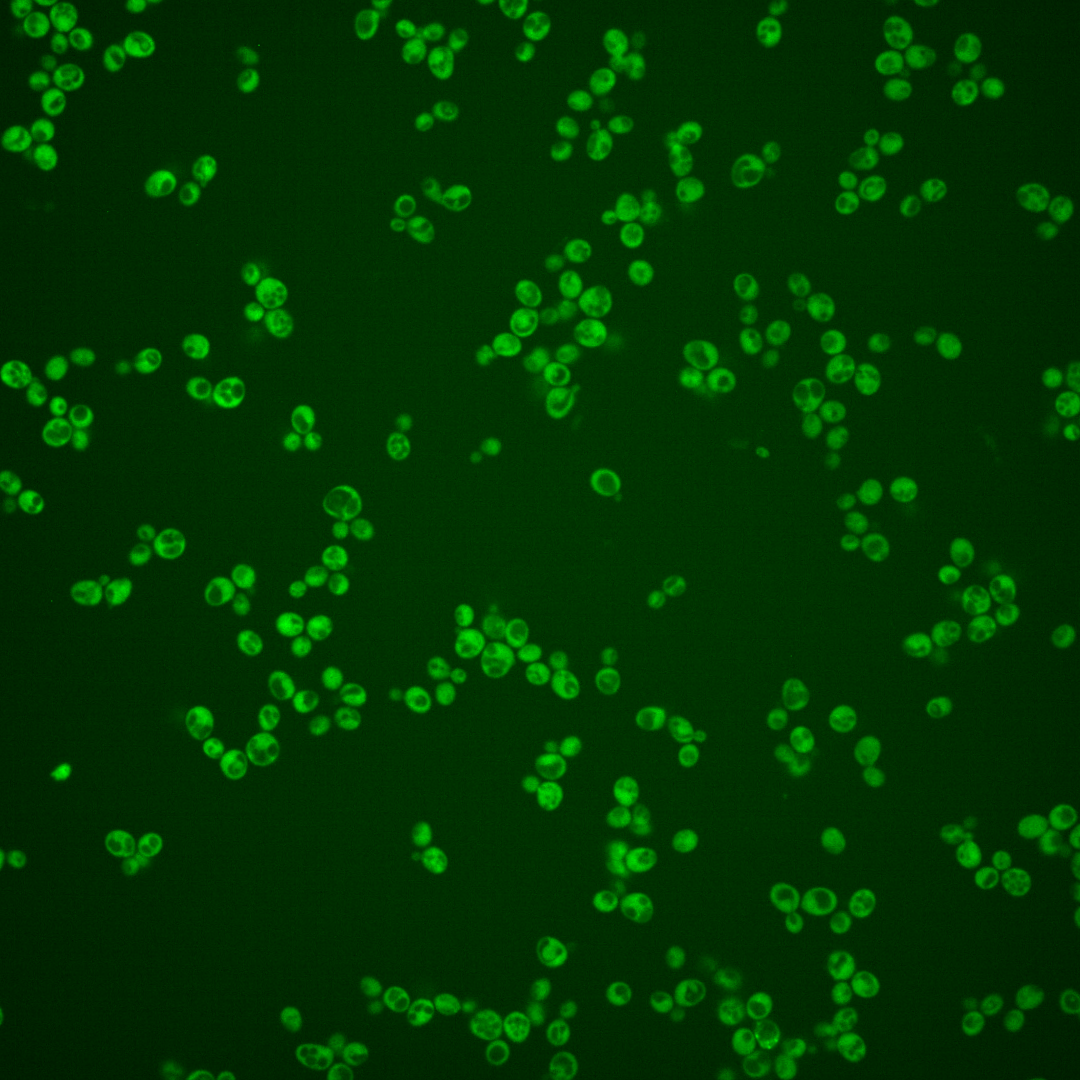
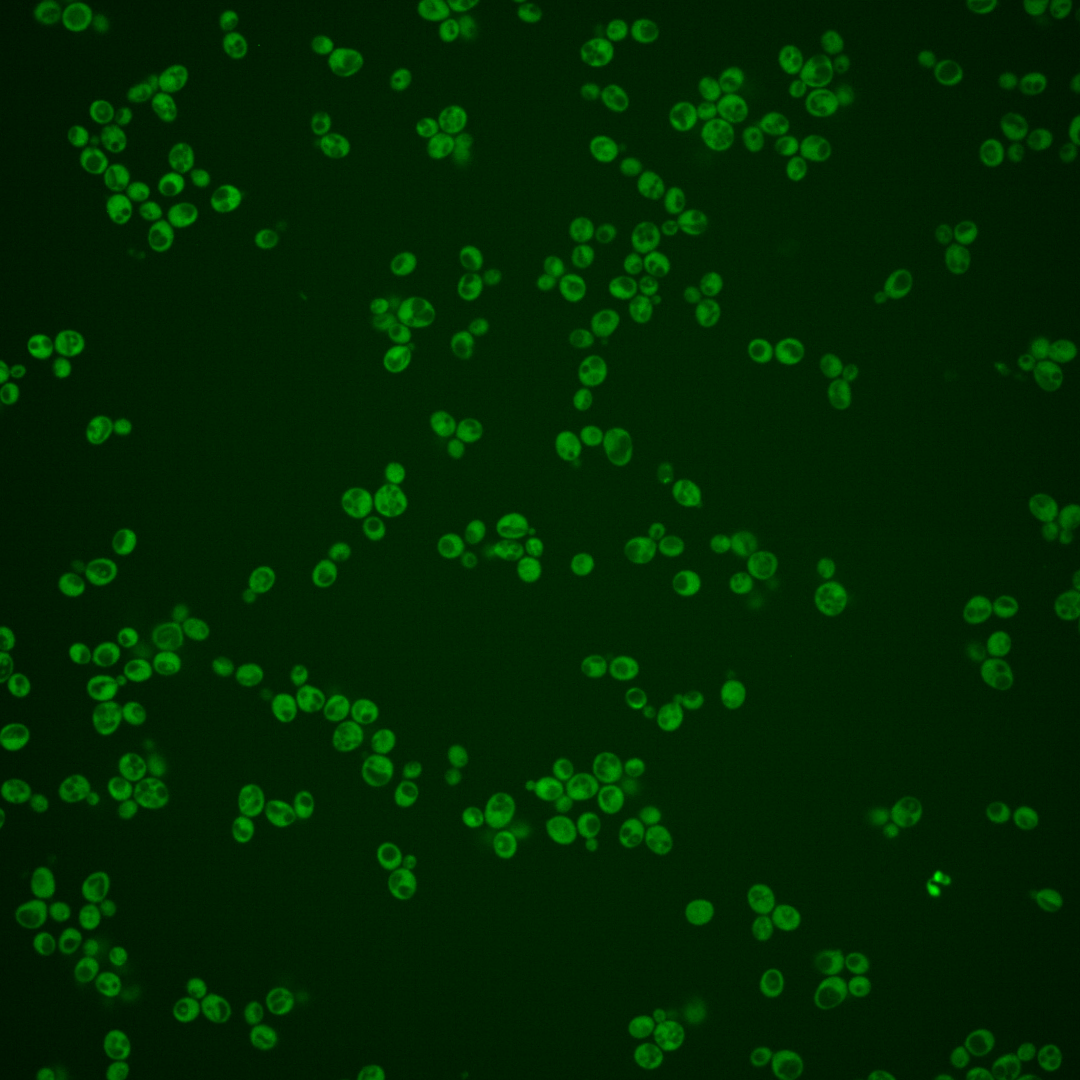
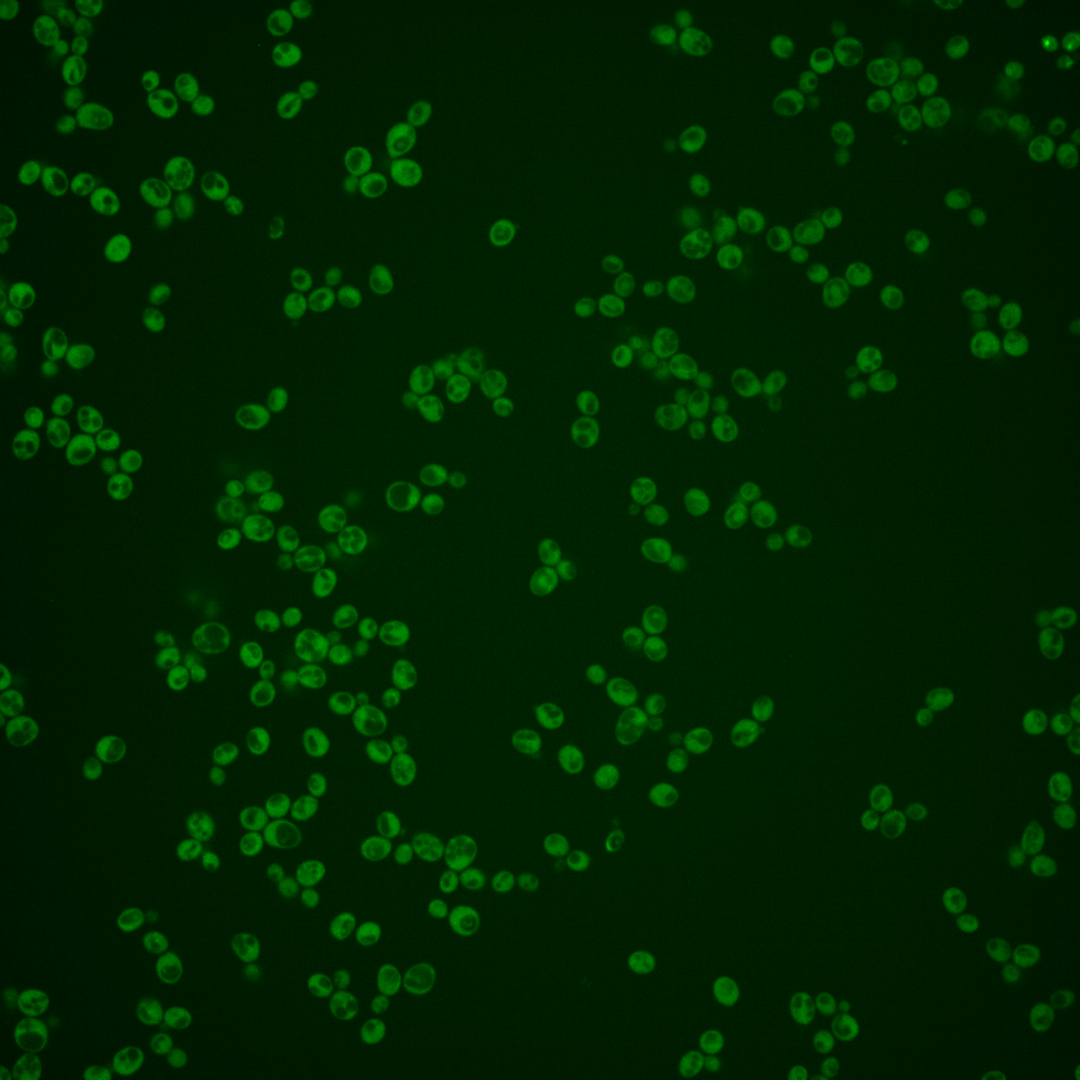
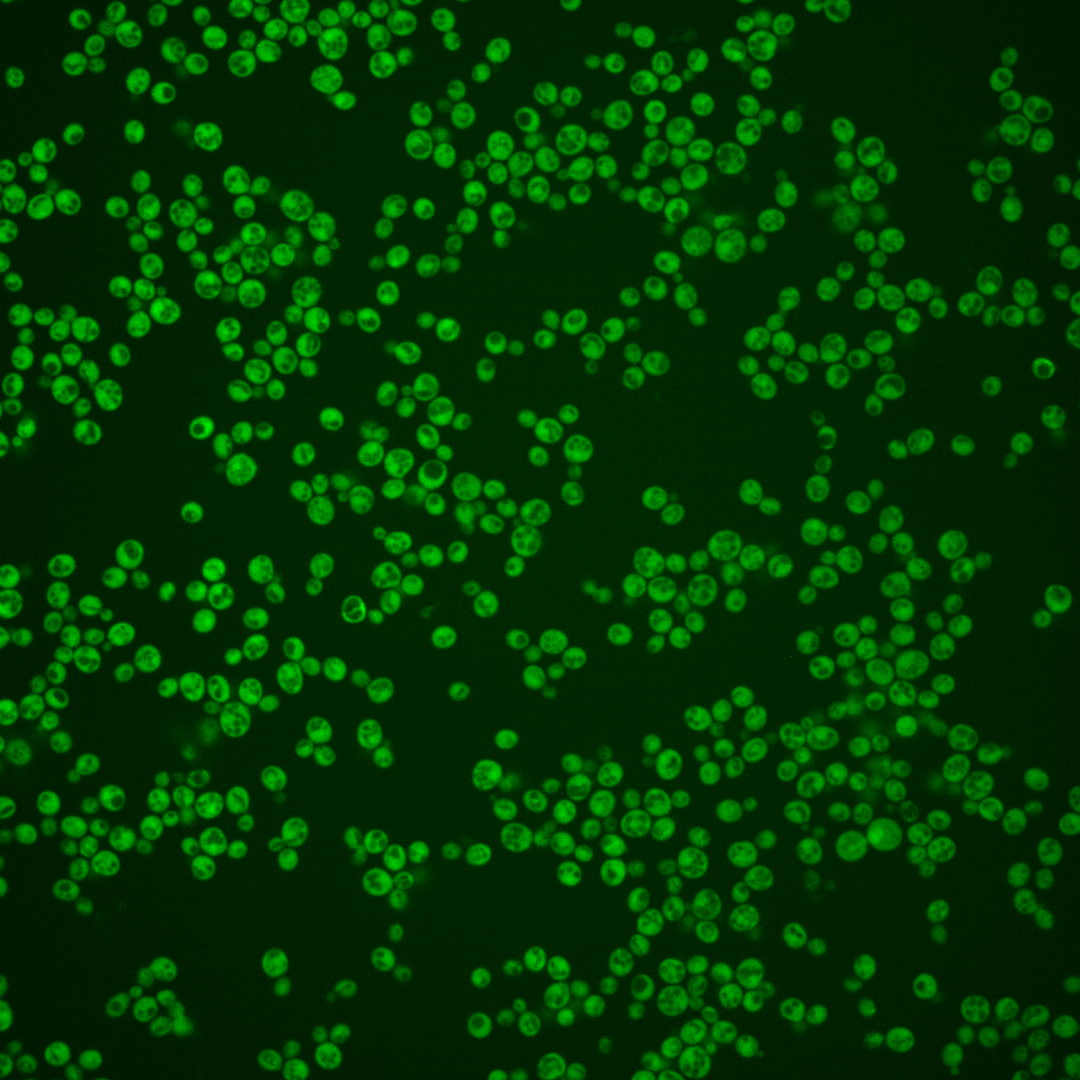
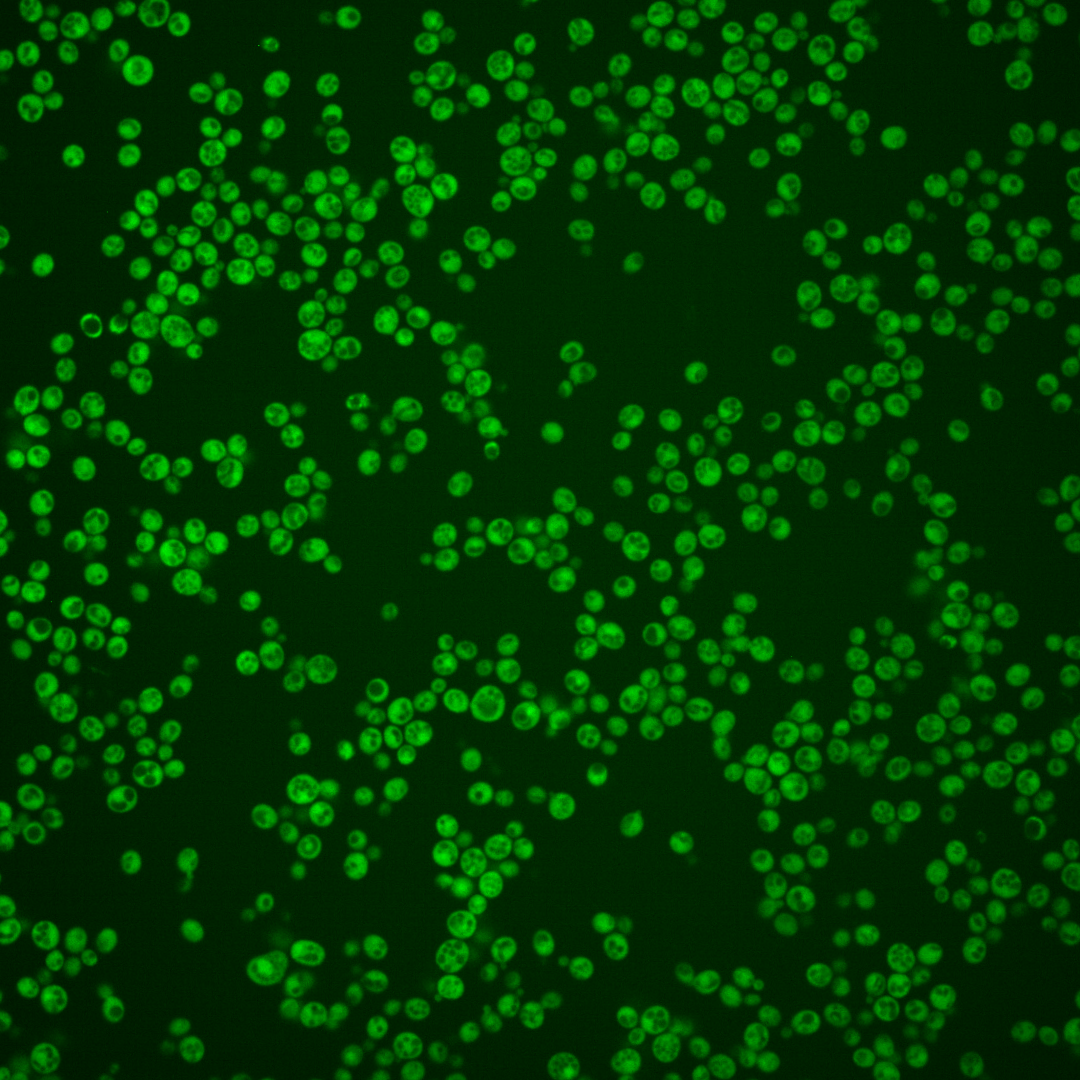
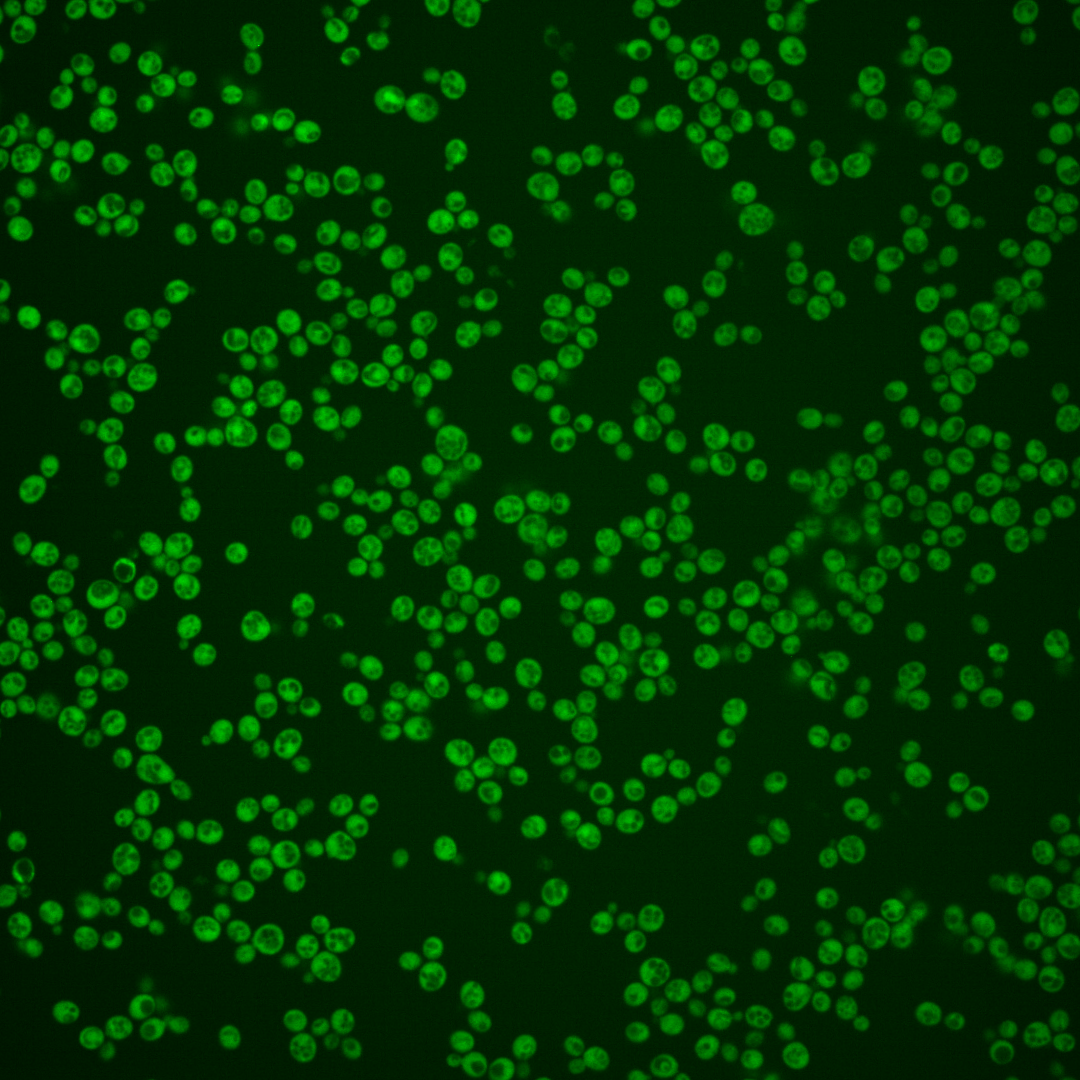
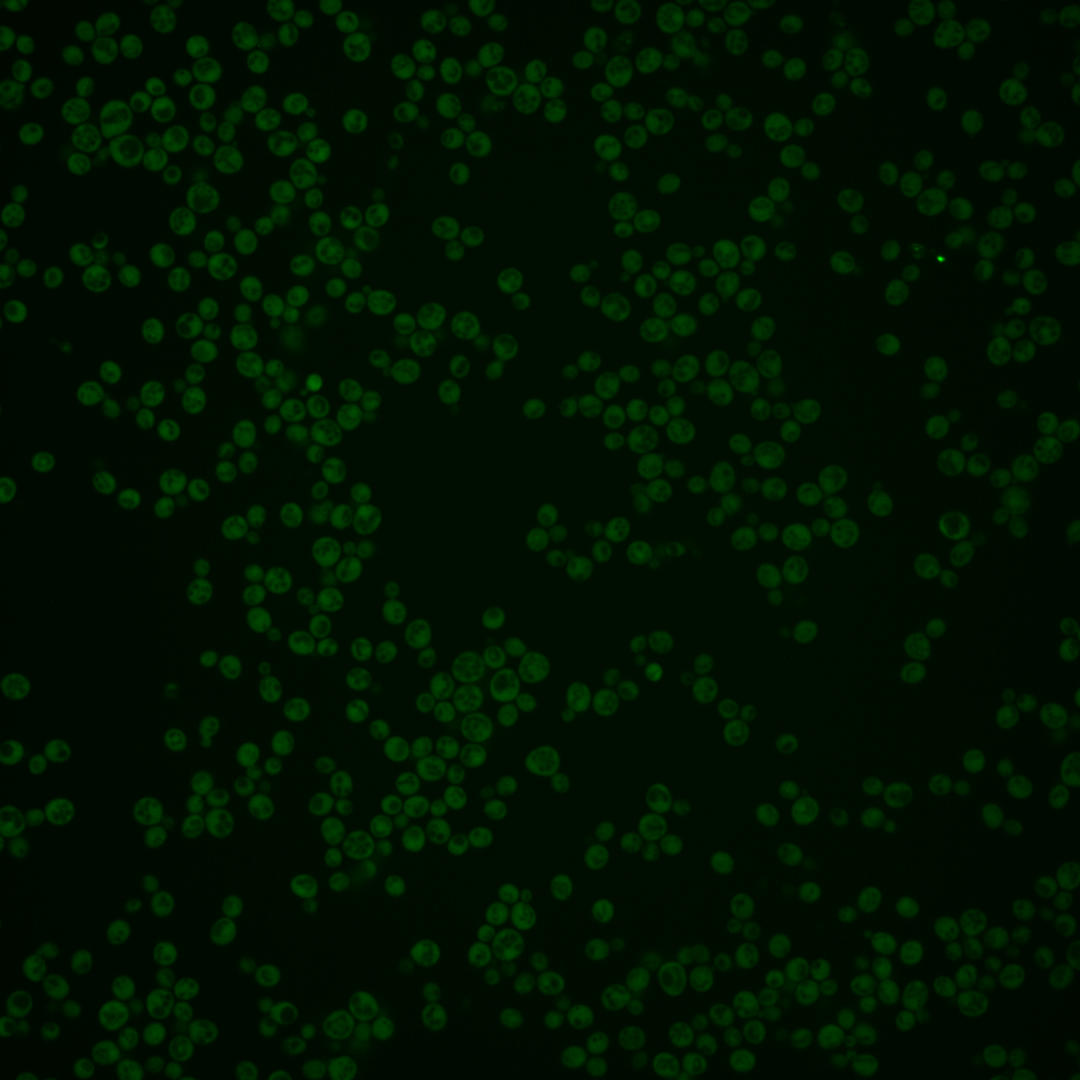

| Standard name | |
|---|---|
| Human Ortholog | |
| Description | Putative RNA binding protein of unknown function; localizes to stress granules induced by glucose deprivation; predicted to be involved in ribosome biogenesis |
Micrographs




















































































Sub-cellular Localization
Yeast GFP Assignment
Protein Abundance
Localization Change
External localization resources
| ensLOC | DeepLoc | |||||||||||||||||||||||
|---|---|---|---|---|---|---|---|---|---|---|---|---|---|---|---|---|---|---|---|---|---|---|---|---|
| Localization | WT1 | WT2 | WT3 | RAP60 | RAP140 | RAP220 | RAP300 | RAP380 | RAP460 | RAP540 | RAP620 | RAP700 | HU80 | HU120 | HU160 | rpd3Δ_1 | rpd3Δ_2 | rpd3Δ_3 | WT1 | WT2 | WT3 | AF100 | AF140 | AF180 |
| Cortical Patches | 0 | 0 | 2 | 0 | 1 | 0 | 1 | 0 | 0 | 0 | 0 | 0 | 0 | 0 | 0 | 0 | 0 | 1 | 0 | 0 | 1 | 0 | 3 | 3 |
| Bud | 0 | 0 | 4 | 0 | 0 | 2 | 3 | 3 | 4 | 9 | 9 | 10 | 2 | 0 | 0 | 0 | 0 | 0 | 0 | 0 | 0 | 0 | 1 | 3 |
| Bud Neck | 0 | 0 | 0 | 0 | 0 | 1 | 1 | 0 | 2 | 1 | 2 | 3 | 0 | 0 | 0 | 0 | 0 | 0 | 0 | 0 | 0 | 0 | 0 | 0 |
| Bud Site | 0 | 0 | 0 | 0 | 0 | 0 | 0 | 0 | 0 | 0 | 0 | 1 | 0 | 0 | 0 | 0 | 0 | 0 | – | – | – | – | – | – |
| Cell Periphery | 2 | 4 | 28 | 6 | 7 | 5 | 9 | 5 | 4 | 4 | 6 | 2 | 2 | 1 | 1 | 4 | 6 | 3 | 0 | 0 | 0 | 0 | 0 | 0 |
| Cytoplasm | 241 | 483 | 607 | 474 | 486 | 571 | 610 | 666 | 503 | 478 | 415 | 478 | 406 | 470 | 457 | 98 | 124 | 63 | 232 | 482 | 630 | 239 | 408 | 331 |
| Endoplasmic Reticulum | 0 | 5 | 7 | 4 | 12 | 10 | 2 | 1 | 3 | 1 | 0 | 2 | 2 | 1 | 3 | 4 | 9 | 1 | 0 | 1 | 7 | 9 | 11 | 10 |
| Endosome | 0 | 0 | 0 | 0 | 0 | 0 | 1 | 0 | 0 | 0 | 0 | 0 | 0 | 0 | 0 | 0 | 0 | 0 | 1 | 2 | 3 | 1 | 2 | 3 |
| Golgi | 0 | 0 | 1 | 0 | 0 | 0 | 0 | 0 | 1 | 0 | 0 | 0 | 0 | 1 | 0 | 0 | 0 | 0 | 1 | 2 | 2 | 0 | 5 | 3 |
| Mitochondria | 1 | 0 | 0 | 1 | 8 | 52 | 80 | 37 | 167 | 162 | 183 | 119 | 0 | 4 | 2 | 1 | 1 | 0 | 2 | 1 | 6 | 3 | 7 | 3 |
| Nucleus | 0 | 1 | 5 | 1 | 3 | 4 | 5 | 17 | 2 | 7 | 9 | 5 | 1 | 1 | 0 | 2 | 0 | 1 | 0 | 2 | 1 | 1 | 0 | 1 |
| Nuclear Periphery | 0 | 0 | 0 | 0 | 0 | 0 | 0 | 1 | 0 | 1 | 0 | 0 | 1 | 0 | 0 | 0 | 1 | 0 | 0 | 0 | 0 | 0 | 0 | 0 |
| Nucleolus | 0 | 0 | 0 | 0 | 0 | 0 | 0 | 0 | 0 | 0 | 3 | 1 | 0 | 0 | 2 | 0 | 0 | 0 | 0 | 0 | 0 | 0 | 0 | 0 |
| Peroxisomes | 0 | 0 | 0 | 0 | 0 | 0 | 0 | 0 | 0 | 0 | 0 | 0 | 0 | 0 | 0 | 0 | 0 | 0 | 0 | 0 | 0 | 0 | 1 | 1 |
| SpindlePole | 0 | 0 | 0 | 0 | 0 | 0 | 2 | 2 | 1 | 2 | 2 | 8 | 0 | 0 | 0 | 0 | 0 | 0 | 0 | 0 | 0 | 0 | 0 | 2 |
| Vac/Vac Membrane | 0 | 2 | 0 | 11 | 13 | 15 | 5 | 40 | 14 | 17 | 11 | 3 | 2 | 7 | 15 | 4 | 1 | 0 | 0 | 3 | 4 | 5 | 8 | 10 |
| Unique Cell Count | 241 | 489 | 626 | 492 | 514 | 625 | 667 | 735 | 601 | 585 | 549 | 577 | 412 | 480 | 472 | 104 | 128 | 66 | 241 | 497 | 661 | 273 | 457 | 382 |
| Labelled Cell Count | 244 | 495 | 654 | 497 | 530 | 660 | 719 | 772 | 701 | 682 | 640 | 632 | 416 | 485 | 480 | 113 | 142 | 69 | 241 | 497 | 661 | 273 | 457 | 382 |
Yeast GFP Assignment
Protein Abundance
| Screen | WT1 | WT2 | WT3 | RAP60 | RAP140 | RAP220 | RAP300 | RAP380 | RAP460 | RAP540 | RAP620 | RAP700 | HU80 | HU120 | HU160 | rpd3Δ_1 | rpd3Δ_2 | rpd3Δ_3 | AF100 | AF140 | AF180 |
|---|---|---|---|---|---|---|---|---|---|---|---|---|---|---|---|---|---|---|---|---|---|
| Mean Cell GFP Intensity (1e-4) | 9.7 | 9.9 | 8.9 | 8.2 | 7.2 | 5.3 | 4.9 | 5.3 | 4.3 | 4.0 | 3.8 | 4.2 | 8.8 | 8.4 | 8.2 | 10.7 | 11.3 | 10.6 | 8.6 | 8.6 | 9.0 |
| Std Deviation (1e-4) | 1.3 | 1.4 | 1.0 | 1.2 | 1.1 | 0.9 | 0.9 | 1.0 | 0.9 | 0.9 | 0.7 | 0.9 | 1.3 | 1.3 | 1.2 | 1.8 | 1.8 | 1.9 | 1.7 | 1.2 | 1.5 |
| Intensity Change (Log2) | – | – | – | -0.12 | -0.29 | -0.75 | -0.85 | -0.75 | -1.06 | -1.17 | -1.24 | -1.07 | -0.02 | -0.08 | -0.12 | 0.26 | 0.35 | 0.25 | -0.04 | -0.04 | 0.02 |
Localization Change
| Localization | RAP60 | RAP140 | RAP220 | RAP300 | RAP380 | RAP460 | RAP540 | RAP620 | RAP700 | HU80 | HU120 | HU160 | rpd3Δ_1 | rpd3Δ_2 | rpd3Δ_3 |
|---|---|---|---|---|---|---|---|---|---|---|---|---|---|---|---|
| Cortical Patches | 0 | 0 | 0 | 0 | 0 | 0 | 0 | 0 | 0 | 0 | 0 | 0 | 0 | 0 | 0 |
| Bud | 0 | 0 | 0 | 0 | 0 | 0 | 0 | 0 | 0 | 0 | 0 | 0 | 0 | 0 | 0 |
| Bud Neck | 0 | 0 | 0 | 0 | 0 | 0 | 0 | 0 | 0 | 0 | 0 | 0 | 0 | 0 | 0 |
| Bud Site | 0 | 0 | 0 | 0 | 0 | 0 | 0 | 0 | 0 | 0 | 0 | 0 | 0 | 0 | 0 |
| Cell Periphery | -3.1 | -3.0 | -4.1 | -3.4 | -4.5 | 0 | 0 | 0 | 0 | -3.8 | -4.4 | -4.4 | 0 | 0.1 | 0 |
| Cytoplasm | -0.6 | -2.0 | -4.2 | -4.2 | -4.7 | -7.9 | -8.7 | -10.9 | -8.2 | 1.6 | 1.0 | -0.1 | -1.4 | -0.1 | -0.7 |
| Endoplasmic Reticulum | 0 | 1.6 | 0.7 | 0 | 0 | 0 | 0 | 0 | 0 | 0 | 0 | 0 | 0 | 0 | 0 |
| Endosome | 0 | 0 | 0 | 0 | 0 | 0 | 0 | 0 | 0 | 0 | 0 | 0 | 0 | 0 | 0 |
| Golgi | 0 | 0 | 0 | 0 | 0 | 0 | 0 | 0 | 0 | 0 | 0 | 0 | 0 | 0 | 0 |
| Mitochondria | 0 | 0 | 7.4 | 8.9 | 5.7 | 0 | 0 | 0 | 0 | 0 | 0 | 0 | 0 | 0 | 0 |
| Nucleus | 0 | 0 | 0 | 0 | 2.2 | 0 | 0.7 | 1.3 | 0 | 0 | 0 | 0 | 0 | 0 | 0 |
| Nuclear Periphery | 0 | 0 | 0 | 0 | 0 | 0 | 0 | 0 | 0 | 0 | 0 | 0 | 0 | 0 | 0 |
| Nucleolus | 0 | 0 | 0 | 0 | 0 | 0 | 0 | 0 | 0 | 0 | 0 | 0 | 0 | 0 | 0 |
| Peroxisomes | 0 | 0 | 0 | 0 | 0 | 0 | 0 | 0 | 0 | 0 | 0 | 0 | 0 | 0 | 0 |
| SpindlePole | 0 | 0 | 0 | 0 | 0 | 0 | 0 | 0 | 0 | 0 | 0 | 0 | 0 | 0 | 0 |
| Vacuole | 0 | 4.0 | 3.9 | 0 | 5.9 | 3.8 | 4.3 | 3.6 | 0 | 0 | 0 | 4.5 | 0 | 0 | 0 |
External localization resources
Images






























Protein Concentration and Protein Localization Data
| R1 | R2 | R3 | ||||||||||||||||
|---|---|---|---|---|---|---|---|---|---|---|---|---|---|---|---|---|---|---|
| G1 Pre-START | G1 Post-START | S/G2 | Metaphase | Anaphase | Telophase | G1 Pre-START | G1 Post-START | S/G2 | Metaphase | Anaphase | Telophase | G1 Pre-START | G1 Post-START | S/G2 | Metaphase | Anaphase | Telophase | |
| Concentration | 4.0391 | 5.2809 | 4.5231 | 3.8029 | 4.001 | 4.6708 | 5.9086 | 7.1986 | 6.3832 | 6.2608 | 6.0734 | 6.1236 | 3.7735 | 4.6171 | 4.3226 | 4.6497 | 3.8549 | 4.4694 |
| Actin | 0.0017 | 0.0004 | 0.0003 | 0.0005 | 0.0001 | 0.0002 | 0.0001 | 0.0001 | 0.0002 | 0.0001 | 0.0002 | 0.0001 | 0.0002 | 0.0006 | 0.0006 | 0.0009 | 0.0007 | 0.0008 |
| Bud | 0.0022 | 0.0005 | 0.0002 | 0.0001 | 0.0001 | 0.0001 | 0.0001 | 0.0001 | 0.0005 | 0.0002 | 0.0002 | 0.0001 | 0 | 0.0001 | 0.0002 | 0.0003 | 0.0001 | 0 |
| Bud Neck | 0.001 | 0.0004 | 0.0003 | 0.0003 | 0.0004 | 0.0011 | 0.0001 | 0.0001 | 0.0003 | 0.0005 | 0.0004 | 0.0006 | 0.0001 | 0.0001 | 0.0059 | 0.0003 | 0.0003 | 0.0004 |
| Bud Periphery | 0.0012 | 0.0002 | 0.0001 | 0 | 0 | 0.0001 | 0 | 0 | 0.0002 | 0.0001 | 0.0001 | 0 | 0 | 0.0001 | 0.0001 | 0.0001 | 0 | 0 |
| Bud Site | 0.0052 | 0.0024 | 0.0004 | 0.0001 | 0.0001 | 0.0001 | 0.0002 | 0.0003 | 0.0007 | 0.0002 | 0.0001 | 0 | 0.0001 | 0.0004 | 0.0008 | 0.0002 | 0.0001 | 0 |
| Cell Periphery | 0.0001 | 0.0001 | 0 | 0 | 0 | 0.0002 | 0 | 0 | 0 | 0 | 0 | 0 | 0 | 0 | 0.0001 | 0.0001 | 0 | 0 |
| Cytoplasm | 0.9171 | 0.9439 | 0.9372 | 0.9308 | 0.9172 | 0.9308 | 0.9655 | 0.9574 | 0.9572 | 0.965 | 0.9789 | 0.9698 | 0.9353 | 0.9821 | 0.9525 | 0.9117 | 0.9754 | 0.9692 |
| Cytoplasmic Foci | 0.0098 | 0.0078 | 0.0073 | 0.0072 | 0.0099 | 0.0134 | 0.0045 | 0.0048 | 0.0073 | 0.0052 | 0.0035 | 0.0058 | 0.0032 | 0.0018 | 0.0033 | 0.0046 | 0.0064 | 0.0045 |
| Eisosomes | 0 | 0 | 0 | 0 | 0 | 0 | 0 | 0 | 0 | 0 | 0 | 0 | 0 | 0 | 0 | 0 | 0 | 0 |
| Endoplasmic Reticulum | 0.0059 | 0.0032 | 0.004 | 0.0086 | 0.0038 | 0.0045 | 0.0032 | 0.0013 | 0.0038 | 0.0081 | 0.0034 | 0.0028 | 0.0054 | 0.0018 | 0.0051 | 0.0389 | 0.0043 | 0.0027 |
| Endosome | 0.011 | 0.0069 | 0.012 | 0.0097 | 0.0232 | 0.0091 | 0.0037 | 0.0062 | 0.0061 | 0.0042 | 0.003 | 0.0045 | 0.0026 | 0.0011 | 0.0098 | 0.0209 | 0.0058 | 0.005 |
| Golgi | 0.0004 | 0.0004 | 0.0004 | 0.0004 | 0.0005 | 0.0003 | 0.0002 | 0.0005 | 0.0004 | 0.0002 | 0.0001 | 0.0001 | 0.0002 | 0.0001 | 0.0003 | 0.0022 | 0.0005 | 0.001 |
| Lipid Particles | 0.0001 | 0.0001 | 0.0001 | 0 | 0 | 0.0001 | 0 | 0 | 0 | 0 | 0 | 0 | 0 | 0 | 0.0007 | 0.0002 | 0 | 0.0013 |
| Mitochondria | 0.0004 | 0.0004 | 0.0004 | 0.0004 | 0.0005 | 0.0006 | 0.0003 | 0.0004 | 0.0004 | 0.0003 | 0.0002 | 0.0004 | 0.0001 | 0.0001 | 0.0002 | 0.0031 | 0.0002 | 0.0021 |
| None | 0.0331 | 0.0208 | 0.0276 | 0.0346 | 0.0369 | 0.0292 | 0.0174 | 0.0153 | 0.0162 | 0.0095 | 0.0048 | 0.0083 | 0.0485 | 0.0094 | 0.0091 | 0.0036 | 0.0025 | 0.009 |
| Nuclear Periphery | 0.002 | 0.0018 | 0.0019 | 0.0018 | 0.0009 | 0.0012 | 0.0008 | 0.0007 | 0.0009 | 0.001 | 0.0005 | 0.0008 | 0.0013 | 0.0005 | 0.003 | 0.0067 | 0.001 | 0.0007 |
| Nucleolus | 0.0001 | 0.0001 | 0.0001 | 0 | 0 | 0 | 0 | 0 | 0 | 0 | 0 | 0 | 0 | 0 | 0.0001 | 0 | 0 | 0 |
| Nucleus | 0.0052 | 0.0074 | 0.0043 | 0.0031 | 0.0039 | 0.0049 | 0.0025 | 0.0113 | 0.0036 | 0.0033 | 0.0028 | 0.0051 | 0.0018 | 0.0011 | 0.0059 | 0.0022 | 0.0017 | 0.0015 |
| Peroxisomes | 0.0001 | 0.0001 | 0.0001 | 0.0001 | 0.0001 | 0.0001 | 0.0001 | 0 | 0.0001 | 0 | 0 | 0 | 0 | 0 | 0 | 0.0001 | 0.0001 | 0.0009 |
| Punctate Nuclear | 0.0009 | 0.001 | 0.0006 | 0.0003 | 0.0002 | 0.0008 | 0.0002 | 0.0003 | 0.0005 | 0.0003 | 0.0001 | 0.0003 | 0.0002 | 0.0001 | 0.001 | 0.0002 | 0.0003 | 0.0003 |
| Vacuole | 0.0023 | 0.0019 | 0.0023 | 0.0015 | 0.0017 | 0.003 | 0.0008 | 0.0007 | 0.0014 | 0.0017 | 0.0013 | 0.0008 | 0.0007 | 0.0004 | 0.0011 | 0.0024 | 0.0005 | 0.0003 |
| Vacuole Periphery | 0.0003 | 0.0003 | 0.0004 | 0.0005 | 0.0005 | 0.0005 | 0.0001 | 0.0002 | 0.0002 | 0.0002 | 0.0003 | 0.0002 | 0.0001 | 0.0001 | 0.0002 | 0.0011 | 0.0002 | 0.0001 |
Sequencing Data
| R1 | R2 | |||||||||
|---|---|---|---|---|---|---|---|---|---|---|
| G1 Post-START | S/G2 | Metaphase | Anaphase | Telophase | G1 Post-START | S/G2 | Metaphase | Anaphase | Telophase | |
| Gene Expression | 46.486 | 30.5959 | 27.4475 | 34.0763 | 34.4407 | 22.4643 | 26.8954 | 21.5027 | 19.439 | 37.9677 |
| Translational Efficiency | 0.8475 | 0.9728 | 1.0935 | 0.5656 | 0.7579 | 1.1185 | 0.926 | 0.7487 | 0.7598 | 0.6445 |
Hit Data
| Dataset | Hit |
|---|---|
| Protein Concentration | ✘ |
| Protein Localization | ✘ |
| Gene Expression | ✘ |
| Translational Efficiency | ✘ |
Endocytosis
| Temp | Actin Patch (Sac6-tdTomato) | Cortical Patch (Sla1-GFP) | Late Endosome (Snf7-GFP) | Vacuole (Vph1-GFP) |
|---|---|---|---|---|
| 37℃ | ||||
| RT |
Cell Cycle Omics
CYCLoPs (Nrp1-GFP)
| Gene / Allele | Actin Patch (Sac6-tdTomato) | Cortical Patch (Sla1-GFP) | Late Endosome (Snf7-GFP) | Vacuole (Sac6-tdTomato) |
|---|
| Gene | Images |
|---|
| Gene | Images |
|---|
Images are not yet available
Images are not yet available